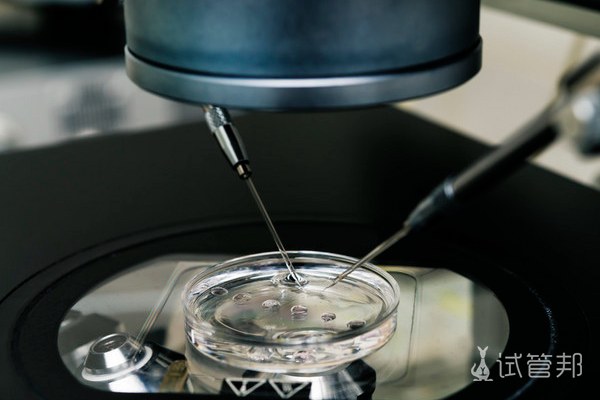
cba7160515f6ef738b48dfa225b2d049.png 第三代试管婴儿能避免什么病

三代试管可以选择男女吗,三代试管是在二代基础上吗
三代试管是在二代试管基础上进一步开发的辅助生殖技术,关於三代試管是否可以選擇男女的問題,一直以來都備受關注。三代試管通過在胚胎移植前進行遗传学诊断,确实可以判断胚胎的性别,但国家规定,除非有特定的医学指征,否则不允许进行性别选择。那么,三代试管可以选择男女吗,三代试管是在二代基础上吗?
第三代试管婴儿能选择性别吗?
第三代试管婴儿技术允许选择宝宝的性别,但仅适用于某些家族遗传性疾病和染色体异常等情况,不能随意选择。该技术通常会对染色体进行檢查,以及對胚胎進行遺傳學診斷,以避免家族遺傳病的出現。
在進行第三代試管嬰兒時,醫生會選取女性的卵子和優質男性精子结合成受精卵,并在培养后对胚胎进行检查。在一些严重影响生存率的家族性疾病情况下,医生可以指导选择婴儿性别,这样可以提高移植成功率并降低遗传病风险。
夫妻双方需共同前往正规医院接受专业检查,医务人员将检测染色体及基因,评估是否能够选择性别。

第三代试管婴儿能避免什么病?
第三代试管婴儿技术可以有效减少多种遗传疾病的风险,但无法完全消除遗传病的发生。该技术主要用于检测胚胎是否携带遗传缺陷基因。
其原理是将精子和卵子在体外结合形成受精卵,经过培养发育成胚胎後,在植入子宮之前進行基因檢測。這使得在移植前就能識別出有缺陷的胚胎,從而顯著降低因胚胎质量问题引发的 complications,如胎停育和流产等。
第三代试管婴儿可以筛查的遗传病包括常染色体显性和隐性遗传病、X连锁遗传病、染色体异常、单基因遗传病(如地中海贫血、血友病)以及多基因遺傳病(如精神分裂症、重症先天性心臟病等)。雖然該技術在預防由染色體和基因引起的遺傳病方面非常有效,但仍无法完全阻止遗传病的发生。
做第三代试管能保证孩子健康吗?
虽然第三代试管婴儿技术可以通过基因检测选择健康胚胎进行移植,但并不能完全保证孩子的健康。该技术的成功率大约在50%-60%之间,受年龄、卵巢功能和子宮條件等因素的影響。
即使經過篩選,仍無法確保胎兒沒有問題。因此,在懷孕期間建议进行唐氏综合症筛查或无创DNA检测,并在必要时考虑羊膜穿刺。
做第三代试管婴儿是不是在第二代试管婴儿基础上?
第三代试管婴儿技术是在第二代试管婴儿的基础上发展而来的。第二代试管婴儿主要关注的是体外受精和胚胎移植,而第三代试管婴儿则进一步引入了基因檢測技術,以篩選出健康的胚胎。這種技術能夠在將胚胎植入母體之前,對其進行遺傳學檢測,從而识别潜在的遗传缺陷。
第三代试管婴儿的关键优势在于它可以显著降低遗传疾病的风险,通过检测常染色体病、X连锁病和其他遗传缺陷,帮助家长选择更加健康的胚胎進行移植。這一過程不僅提高了懷孕成功率,還減少了後期妊娠併發症的發生。因此,第三代試管婴儿技术是对以往方法的重要补充和提升。
对于三代试管可以选择男女吗,三代试管是在二代基础上吗?这些问题,三代试管技术虽然可以判断胚胎的性别,但非医学指征下的性别选择是被禁止的。三代试管在二代試管的基礎上引入了胚胎評估和篩查等先進技術,提高了妊娠成功率並降低了遺傳性疾病的风险。这一技术为不孕夫妇提供了更多希望和选择,但必须在法律和伦理的框架内进行。
-
试管婴儿高成功率
点击查看
-
试管婴儿费用/流程
获取详情
-
第三代试管医院
汇总收藏
-
试管婴儿补贴
领取优惠